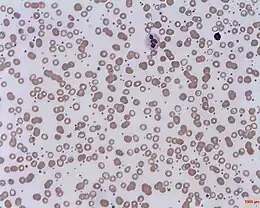
Description de cette image, également commentée ci-après

Thrombocytose
Thrombocytose
L'examen direct du sang révèle un compte de plaquettes plus élevé qu'à la normale : c'est la thrombocytose.
| Médicament | Uramustine, chlorambucil, hydroxyurée, ruxolitinib et Anagrélide |
|---|---|
| Spécialité | Hématologie |
| CIM-10 | D75.8 |
|---|---|
| CIM-9 | 289.9 |
| DiseasesDB | 27591 |
| MedlinePlus | 000543 |
| eMedicine |
206811 ped/2238 |
| MeSH | D013922 |
| Patient UK | Thrombocytosis |
![]() Mise en garde médicale
Mise en garde médicale
La thrombocytose (ou hyperplaquettose, ou encore thrombocytémie, thrombocythémie) est une anomalie de l'hémogramme caractérisée par une augmentation du nombre de plaquettes circulantes.
Diagnostic et complications
Le diagnostic est essentiellement biologique avec la découverte à l'hémogramme d'un nombre de plaquettes supérieur à 500 000/µl.
Cliniquement, on note une splénomégalie inconstante.
Les complications spécifiques d'une thrombocytose sont les hémorragies et les thromboses veineuses et artérielles.
Critères diagnostiques de la thrombocytémie essentielle
Critères diagnostiques de thrombocytémie essentielle, établis par la Polycythemia Vera Study Group en 1997 :
- numération des plaquettes supérieure à 600 000/mm³
- hématocrite inférieur à 50 % pour un homme et 45 % pour une femme
- présence de fer médullaire, ferritinémie normale ou VGM normal
- pas de chromosome Philadelphie
- absence de fibrose médullaire
- pas d'élément cytologique d'un syndrome myélodysplasique
- absence d'étiologie de thrombocytose réactionnelle
Étiologie
- Hyperplaquettose primitive ou essentielle :
- syndrome myélodysplasique,
- thrombocytémie et autres
- syndromes myéloprolifératifs.
- Hyperplaquettose secondaire ou réactionnelle à :
- une maladie inflammatoire,
- une carence martiale,
- une asplénie et splénectomie,
- un cancer,
- un stress ou diverses asthénies.
Notes et références
Voir aussi
- Portail de la médecine
- Portail de l’hématologie
Cet article est issu de Wikipedia. Le texte est sous licence Creative Commons – Attribution – Partage à l’identique. Des conditions supplémentaires peuvent s’appliquer aux fichiers multimédias.